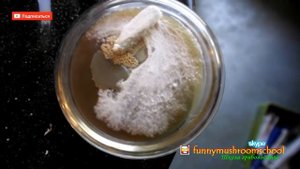

3:40
3:40
2025-10-04 10:24

 19:30
19:30
19:30
19:30
2023-12-06 20:23

 1:42
1:42

 1:42
1:42
2024-05-03 18:21

 2:10
2:10

 2:10
2:10
2024-01-16 19:29

 3:58
3:58

 3:58
3:58
2023-11-17 21:18

 8:23
8:23

 8:23
8:23
2023-12-10 02:53

 2:26
2:26

 2:26
2:26
2023-11-13 05:32

 4:04
4:04

 4:04
4:04
2023-11-25 09:34
![Компактная противоугонная сигнализация для вело и мото техники [видео к статье]](https://pic.rutubelist.ru/video/2025-10-02/4b/b0/4bb0f3f32cc4cbccdfea34b7d3b989c9.jpg?width=300)
 4:17
4:17
![Компактная противоугонная сигнализация для вело и мото техники [видео к статье]](https://pic.rutubelist.ru/video/2025-10-02/4b/b0/4bb0f3f32cc4cbccdfea34b7d3b989c9.jpg?width=300)
 4:17
4:17
2025-10-02 20:40

 5:06
5:06

 5:06
5:06
2025-05-23 09:06
![[YBA] The World Over Heaven Review and Combos.](https://pic.rutubelist.ru/video/ac/2a/ac2ae587f653589503d7c90b7d385855.jpg?width=300)
 3:59
3:59
![[YBA] The World Over Heaven Review and Combos.](https://pic.rutubelist.ru/video/ac/2a/ac2ae587f653589503d7c90b7d385855.jpg?width=300)
 3:59
3:59
2024-03-21 03:56

 10:21
10:21

 10:21
10:21
2023-09-22 12:16

 3:35
3:35

 3:35
3:35
2022-04-06 09:02

 35:02
35:02

 35:02
35:02
2022-03-11 14:11

 10:14
10:14

 10:14
10:14
2023-08-15 20:00

 4:59
4:59

 4:59
4:59
2022-03-21 20:02

 3:45
3:45

 3:45
3:45
2021-04-13 10:31

 21:49
21:49
![Ганишер Раззоков - Дилижон (Премьера клипа 2025)]() 3:46
3:46
![Премьера! Ваня Дмитриенко и Аня Пересильд - Силуэт (OST «Алиса в Стране Чудес»)]() 2:47
2:47
![Magas - Без тебя (Премьера клипа 2025)]() 2:28
2:28
![Lx24 - Сберегу (Премьера клипа 2025)]() 2:57
2:57
![TASSO - Таю (Премьера клипа 2025)]() 3:23
3:23
![Taylor Swift - The Fate of Ophelia (Official Video 2025)]() 3:58
3:58
![Олег Семенов - Бархатный сезон (Премьера клипа 2025)]() 3:51
3:51
![UMARO, Сангин - Брат мой (Премьера клипа 2025)]() 3:16
3:16
![ХАБИБ - Шаганэ (Премьера клипа 2025)]() 2:49
2:49
![Анвар Нишонов - Тулкилар (Премьера клипа 2025)]() 3:38
3:38
![Премьера клипа! ХАБИБ - Шаганэ]() 2:49
2:49
![INSTASAMKA - AGENT GIRL (Премьера клипа 2025)]() 3:24
3:24
![Xeko - Увы, чужая (Премьера клипа 2025)]() 2:10
2:10
![Эльдар Долаев - Ранила (Премьера клипа 2025)]() 3:02
3:02
![Джиган - Раз и навсегда (Премьера клипа 2025)]() 2:37
2:37
![Владимир Ждамиров - Чифирок (Премьера клипа 2025)]() 3:49
3:49
![Премьера клипа! NEMIGA, NAVAI - Пойдем в кино]() 2:47
2:47
![Шохжахон Рахмиддинов - Бевафолик килдинга (Премьера клипа 2025)]() 4:15
4:15
![Gazan, Бабек Мамедрзаев - Танцуй моя королева (Премьера клипа 2025)]() 2:29
2:29
![Динара Швец - Новая история (Премьера клипа 2025)]() 3:45
3:45
![Добыча (2022)]() 1:45:08
1:45:08
![Последний клиент]() 1:33:23
1:33:23
![Стив | Steve (2025)]() 1:33:34
1:33:34
![Аббатство Даунтон 3 (2025)]() 2:03:57
2:03:57
![101 далматинец: Все части 1, 2 (фильмы)]() 3:46:00
3:46:00
![Большое смелое красивое путешествие (2025)]() 1:49:16
1:49:16
![101 далматинец (фильм, 1996) | Круэлла и далматинцы]() 2:12:42
2:12:42
![Некая справедливость (2014)]() 1:32:52
1:32:52
![Миссия невыполнима: Финальная расплата (2025)]() 2:52:55
2:52:55
![Чумовая пятница 2 | Freakier Friday (2025)]() 1:50:38
1:50:38
![Девушка из каюты №10 | The Woman in Cabin 10 (2025)]() 1:35:11
1:35:11
![Волынь (2016)]() 2:28:56
2:28:56
![Ниже нуля (2021) Netflix]() 1:46:35
1:46:35
![Монстры: История Эда Гейна (2025) (мини-сериал)]() 7:26:60
7:26:60
![Облако (2024)]() 2:04:02
2:04:02
![Комната (2003)]() 1:39:52
1:39:52
![Скелеты Железного острова]() 1:25:19
1:25:19
![Doom (2005) (Расширенная версия)]() 1:52:44
1:52:44
![История моей жены]() 2:42:50
2:42:50
![Порочный круг (2025)]() 1:43:41
1:43:41
![Гномео и Джульетта (2011) / Gnomeo & Juliet]()
 1:23:51
1:23:51
![Альфа и Омега: Клыкастая братва (2010) / Alpha and Omega]()
 1:27:56
1:27:56
![Науэль и волшебная книга (2020) / Nauel and the Magic Book]()
 1:37:06
1:37:06
![Альфа и Омега 4: Легенда о Зубастой Пещере (2014) / Alpha and Omega 4]()
 45:14
45:14
![Барби: Скиппер и большое приключение с детьми (2023) / Skipper and the Big Babysitting Adventure]()
 1:02:58
1:02:58
![Волшебный парк Джун (2019) / Wonder Park]()
 1:25:17
1:25:17
![Смурфики (2011) / The Smurfs]()
 1:42:44
1:42:44
![Ночная жуть Тайни Тун (1995) / Tiny Toon Night Ghoulery]()
 43:38
43:38
![ЛЕГО Манки Кид: Рождение героя (2020) / Lego Monkie Kid: A Hero Is Born]()
 45:00
45:00
![Земля до начала времён 3: В поисках воды (1995) / The Land Before Time III]()
 1:10:48
1:10:48
![Лоракс (2012) / The Lorax]()
 1:26:13
1:26:13
![Плохие парни 2 (2025) / The Bad Guys 2]()
 1:43:47
1:43:47
![Дорога домой (2021) / Back to the Outback]()
 1:31:40
1:31:40
![Земля до начала времён 2: Приключения в Великой Долине (1994) / The Land Before Time II]()
 1:13:31
1:13:31
![Союз зверей (2010) / Animals United]()
 1:33:07
1:33:07
![Земля до начала времён 5: Таинственный остров (1997) / The Land Before Time V]()
 1:13:30
1:13:30
![Иллюзионист (2010) / L'illusionniste]()
 1:19:53
1:19:53
![Альфа и Омега 3: Большие Волчьи Игры (2013) / Alpha and Omega 3: The Great Wolf Games]()
 45:01
45:01
![Шерлок Гномс (2018) / Sherlock Gnomes]()
 1:26:19
1:26:19
![Земля до начала времён 13: Сила дружбы (2007) / The Land Before Time XIII]()
 1:15:39
1:15:39

 21:49
21:49Скачать видео
| 256x144 | ||
| 426x240 | ||
| 640x360 | ||
| 854x480 | ||
| 1280x720 | ||
| 1920x1080 |
 3:46
3:46
2025-10-14 11:30
 2:47
2:47
2025-10-10 09:59
 2:28
2:28
2025-10-17 12:00
 2:57
2:57
2025-10-11 12:26
 3:23
3:23
2025-10-16 10:00
 3:58
3:58
2025-10-17 11:48
 3:51
3:51
2025-10-16 10:57
 3:16
3:16
2025-10-10 13:04
 2:49
2:49
2025-10-10 12:36
 3:38
3:38
2025-10-11 12:45
 2:49
2:49
2025-10-10 09:59
 3:24
3:24
2025-10-17 11:33
 2:10
2:10
2025-10-10 12:50
 3:02
3:02
2025-10-10 12:56
 2:37
2:37
2025-10-10 12:33
 3:49
3:49
2025-10-16 10:37
 2:47
2:47
2025-10-10 09:59
 4:15
4:15
2025-10-09 09:22
 2:29
2:29
2025-10-11 12:10
 3:45
3:45
2025-10-15 10:45
0/0
 1:45:08
1:45:08
2025-10-06 12:51
 1:33:23
1:33:23
2025-10-13 11:36
 1:33:34
1:33:34
2025-10-08 12:27
 2:03:57
2:03:57
2025-10-05 21:44
 3:46:00
3:46:00
2025-10-14 19:14
 1:49:16
1:49:16
2025-10-17 13:42
 2:12:42
2:12:42
2025-10-14 17:28
2025-10-13 04:45
 2:52:55
2:52:55
2025-10-05 20:57
 1:50:38
1:50:38
2025-10-16 16:08
 1:35:11
1:35:11
2025-10-13 12:06
 2:28:56
2:28:56
2025-10-08 21:04
 1:46:35
1:46:35
2025-10-14 21:34
 7:26:60
7:26:60
2025-10-05 20:29
 2:04:02
2:04:02
2025-10-12 13:06
 1:39:52
1:39:52
2025-10-08 18:11
 1:25:19
1:25:19
2025-10-13 11:18
 1:52:44
1:52:44
2025-10-09 20:16
 2:42:50
2:42:50
2025-10-13 11:40
 1:43:41
1:43:41
2025-10-13 12:39
0/0

 1:23:51
1:23:51
2025-09-10 18:00

 1:27:56
1:27:56
2025-09-16 18:00

 1:37:06
1:37:06
2025-10-05 18:00

 45:14
45:14
2025-10-12 18:00

 1:02:58
1:02:58
2025-09-07 18:00

 1:25:17
1:25:17
2025-09-08 18:00

 1:42:44
1:42:44
2025-09-27 18:00

 43:38
43:38
2025-09-09 18:00

 45:00
45:00
2025-10-07 18:00

 1:10:48
1:10:48
2025-09-15 18:00

 1:26:13
1:26:13
2025-09-14 18:00

 1:43:47
1:43:47
2025-09-23 18:00

 1:31:40
1:31:40
2025-09-12 18:00

 1:13:31
1:13:31
2025-09-13 18:00

 1:33:07
1:33:07
2025-10-15 18:01

 1:13:30
1:13:30
2025-09-20 18:00

 1:19:53
1:19:53
2025-10-11 18:00

 45:01
45:01
2025-10-10 18:00

 1:26:19
1:26:19
2025-09-25 18:00

 1:15:39
1:15:39
2025-10-06 18:00
0/0

